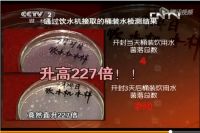
​3天细菌暴增227倍！揭露桶装水菌落超标真相！

02/27/2020 13:35
上海的樱花已经开了,草长莺飞的春天已经悄咪咪在路上了,在家等好消息的大家心里都满怀希望,那么再告诉大家一个超级好消息!苏宁小Biu智慧屏参加苏宁三月开门红活动啦!福利多多!优惠多多!绝对是这个春天的...
>> 查看全文
[家居资讯] “金莲花”杯设计创新人物奖--新锐设计师
02/27/2020 13:31
为推动设计行业的交流与合作,在澳门特区政府相关主管部门的大力支持下,澳门国际设计联合会举办的澳门国际设计联展,利用澳门“走出去”与“引进来”国际化交流平台的作用,汇聚粤港澳台、新加坡等东盟国家、葡萄...
>> 查看全文
[家居资讯] 3天细菌暴增227倍!揭露桶装水菌落超标真相!
02/27/2020 12:46
鉴于饮用自来水的安全风险问题,为了抵御水污染,也为了饮水方便,有些家庭、企事业单位、政府机构,乃至学校仍在饮用桶装水。那么,用上了桶装水,就真的能远离水污染吗?真的未必! 近年来关于桶装水...
>> 查看全文
[家居资讯] 硬核企业“喜梦宝” 3次捐赠助战“疫”
02/27/2020 12:32
2月10日,一辆辆满载着医疗用品大纸箱的大型运输车从深圳紧急驶往武汉,车上装着厦门喜梦宝家居集团从柬埔寨、泰国、越南等东南亚国家紧急采购的价值52.5万元的15万副医用口罩。为尽快将这批救命口罩运到...
>> 查看全文
02/27/2020 11:51
没有臃肿的衣服束缚,孩子们光着脚丫,大人则席地而坐,各自做着自己喜欢的事,完全不用担心着凉,即使窗外白雪皑皑,仍能感受到春日般的温暖与舒适,你向往这样的冬日生活吗? 答案是肯定的,这也是越...
>> 查看全文